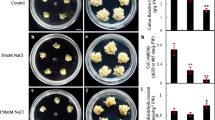

Abstract
Callus of the halophyte Nitraria tangutorum Bobr. was used to investigate proline metabolism and its signal regulation under salinity stress. Enhanced levels of proline and hydrogen peroxide (H2O2) were observed in calli exposed to salinity stress, and elevated levels of calcium (Ca) were detected in early responses to 75 mM NaCl treatment. Additionally, NaCl treatment induced significant elevation of ornithine-δ-aminotransferase (OAT) activity, but notable decreases occurred in the activities of glutamyl kinase (GK) and proline dehydrogenase (PDH). H2O2 scavenger dimethylthiourea and pyruvate inhibited the accumulation of proline and the stimulation of OAT in salinity-stressed calli. Moreover, the utilization of Ca chelator EGTA and Ca channel blocker verapamil abolished the enhancement of proline level induced by 75 mM NaCl treatment for 3 days. These results suggest that the accumulation of proline is correlated to the increase of OAT activity and the decrease of PDH activity in response to salinity, and that elevated Ca signal during the early stage of NaCl treatment and the excitation of OAT activity resulting from the increase of H2O2 generation are essential for proline accumulation in salinity-stressed calli.
Similar content being viewed by others
Explore related subjects
Discover the latest articles, news and stories from top researchers in related subjects.Avoid common mistakes on your manuscript.
Introduction
High salt concentration in soils is one of the factors responsible for the decreases in plant growth and crop productivity in many regions of the world (Perez-Alfocea et al. 1996). Accumulation of proline is widely observed when plants are exposed to salt stresses (Kavi Kishor et al. 2005; Banu et al. 2009; Wang et al. 2011). Some researchers suggest that the elevation of proline level is merely due to stress reaction but not a mechanism for the increase of salt tolerance (Widholm 1988; Ashraf 1989). This idea is further supported by accumulating higher concentration of proline in sensitive rice cultivars than in tolerant genotypes under salt stress (Lutts et al. 1999). However, significant roles of proline involved in salt adaptation or salt tolerance have been demonstrated in some plants and cell cultures (Banu et al. 2009; Lokhande et al. 2010; Sekmen et al. 2012). A series of experiments provide the important evidence that the accumulation of proline can be used as a biochemical marker for the increase of salt tolerance in transgenic plants (Gleeson et al. 2005; Chen et al. 2007). For example, the study of Du et al. (2012) showed that transgenic plants of Populus tomentosa adapted to high salt stress environment and accumulated proline, and that the overall salt tolerance was improved considerably.
Proline accumulation can be due to an increase in proline biosynthesis, via two different pathways from either glutamate or ornithine/ariginine (Kavi Kishor et al. 2005), and a decrease in proline degradation. Glutamyl kinase (GK) is a rate-limiting step in the glutamate pathway, and ornithine δ-aminotransferase (OAT) is a key enzyme which catalyses the first step in the ornithine pathway (Yang et al. 2009). In general, proline accumulation is associated with increased synthesis from glutamate (Misra and Gupta 2005). On the other hand, other investigations have suggested that the ornithine pathway, via an increase of OAT activity, contributes to proline synthesis when plants are treated with salinity (Madan et al. 1995; Krell et al. 2007). In addition, proline degradation catalysed by proline dehydrogenase (PDH) is involved in the accumulation of proline in response to salinity stress. For example, in Saussurea amara seedlings, salinity-induced proline accumulation is accompanied by a decrease in the activity of PDH (Wang et al. 2011).
Although previous studies have demonstrated the importance of proline accumulation in the adaptive response of plants to osmotic stress (Ashour and Mekki 2006; Megdiche et al. 2007), molecular signals involved in the regulation of proline metabolism are still poorly understood. An investigation on the role of abscisic acid (ABA) in the regulation of proline synthesis suggests that endogenous ABA content may affect proline accumulation in Arabidopsis thaliana under salt stress (Savoure et al. 1997). Calcium (Ca) plays a role as a signaling molecule in a number of plant responses to environmental stresses. By identifying the potential components of the signaling pathways required for the regulation of proline accumulation, Parre et al. (2007) suggested that Ca signal via phospholipase C is essential for proline accumulation under ionic hyperosmotic stresses in Arabidopsis. However, phospholipase D is a negative regulator of proline biosynthesis in Arabidopsis thaliana (Thiery et al. 2004). Hydrogen peroxide (H2O2) is also considered as a signal molecule regulating many important plant processes to different stresses including salinity. In a recent study, exogenous H2O2 treatment leads to a significant accumulation of proline in coleoptiles and radicles of maize seedlings (Yang et al. 2009), implying that H2O2 may participate in signal transduction events involved in the regulation of proline metabolism. These studies provide the evidence that various signals are responsible for regulating proline metabolism in response to different environmental stresses in some plants, whereas the causal link between H2O2 production and the changes of Ca content involved in the regulation of proline accumulation has seldom been studied in plants exposed to salinity stress.
Nitraria tangutorum Bobr. is a typical desert halophyte growing under extreme conditions in northwest China, which plays an important ecological function because of its superior tolerance to severe drought and high salinity. However, there are few researches on physiological adaptative responses of Nitraria tangutorum Bobr. to salt environment. More recently, our studies indicated that calli from Nitraria tangutorum Bobr. are an ideal material for studies on the adaptation of plants to salinity stress (Yang et al. 2010a) and that the higher activity of antioxidant enzymes plays an important role in salt tolerance of Nitraria Tangutorum Bobr. calli (Yang et al. 2010b). In this study, we used callus of Nitraria tangutorum Bobr. to investigate proline metabolism and its signal regulation in response to salinity stress.
Materials and methods
Plant material and growth conditions
Seeds of Nitraria tangutorum Bobr. were obtained from Minqin Desert Botanical Garden of Gansu Province. The seeds were surface sterilized for 12 s with 75 % (v/v) ethanol, and then in 0.1 % (w/v) HgCl2 for 10 min, the seeds were rinsed for 6 times with sterile distilled water. The embryos were extracted and incubated on 30 ml of growth regulator-free Murashige and Skoog (MS) solid medium. Callus was induced and subcultured as described in detail previously by Yang et al. (2010b).
NaCl (75, 150 and 300 mM), dimethylthiourea (DMTU, 5 mM), pyruvates (5 mM), ethylene glycol bis-(beta-aminoethyl ether)-N,N,N′,N′-tetra-acetic acid (EGTA, 4 mM) and verapamil (10 μM) were added in the MS medium. Calli were maintained at 24 °C ± 1.5 °C under a light irradiance of 150 μmol m−2 s−1 (10 h-photo period) for different days according to the experiment, then collected and washed by distilled water, the excess water was blotted with filter paper.
Proline measurement
After 3, 6 and 9 days of culture on MS medium containing 0.3 mg l−1 6-BA, 1 mg l−1 NAA and different NaCl concentrations (0, 75, 150 or 300 mM), calli were collected for the measurement of proline content according to Bates et al. (1973) with some modifications. Fresh calli (0.5 g) were immediately homogenized in 5 ml of 3 % sulfosalicylic acid solution, and then heated at 98 °C for 10 min. After centrifugation at 15,000g for 15 min, 0.25 ml supernatant was added to 3.75 ml of the reaction medium containing 0.56 % sulfosalicyclic acid, 0.25 % glacial acetic acid and 1.25 % ninhydrin solution. The mixture was kept at 95 °C for 60 min, and then the reaction was stopped quickly by an ice bath. Toluene (4 ml) was added to the mixture, and the organic phase was extracted and monitored at 520 nm by spectrophotometer.
Proline metabolism enzyme activity measurement
Calli cultured for 3, 6 and 9 days on MS medium containing 0.3 mg l−1 6-BA, 1 mg l−1 NAA and different NaCl concentrations (0, 75, 150 or 300 mM) were collected in order to analyze OAT (EC 2.6.1.13), GK (EC 2.7.2.11) and PDH (EC 1.5.99.8) activities.
About 1 g of calli was immediately homogenized in 100 mM potassium phosphate buffer (pH 7.9) containing 1 mM ethylenediamine tetraacetic acid (EDTA), 15 % glycerol and 10 mM 2-mercaptoethanol. The homogenate was centrifuged at 15,000g for 15 min at 4 °C and the supernatant was collected for OAT activity measurement. OAT activity was assayed with ninhydrin according to Kim et al. (1994). One ml of the reaction mixture composed 50 mM Tris–HCl (pH 8.0), 50 mM l-ornithine, 5 mM β-ketoglutarate, 0.05 mM pyridoxal phosphate and the appropriate amount of crude enzyme extraction was incubated at 37 °C for 20 min. After adding 0.3 ml of 3 N perchloric acid and 0.2 ml of 2 % ninhydrin, the reaction was stopped by boiling for 5 min. The precipitate was collected by centrifugation (13,000g, 30 min, 4 °C) and completely dissolved with 1.5 ml of ethanol, and then the absorbance was recorded at 510 nm. The absorbance of 0.01 at 510 nm was defined as one unit (U) of OAT activity, and the specific enzyme activity was expressed as U mg−1 protein.
About 2 g of calli was ground in 2 ml TD buffer (50 mM Tris–HCl buffer, pH 7.0, 1 mM dithiothreitol and 10 % glycerol). After centrifugation at 16,000g for 20 min, the supernatant was collected and precipitated by adding solid ammonium sulphate (40 % saturation). And then, the soluble fraction obtained by centrifugation (16,000g for 20 min) was saturated with dry ammonium sulphate to a concentration of 80 %. After centrifugation at 15,000g for 15 min at 4 °C, the pellet was collected and completely dissolved with 1 ml TD buffer. The crude enzyme solution was obtained after a 24 h dialysis against TD buffer at 4 °C and GK activity was assayed by the method of Smith et al. (1984) with some modifications. A total volume of 1 ml assay mixture containing 50 mM glutamate, 10 mM ATP, 20 mM MgCl2, 100 mM oxammonium hydrochloride, 50 mM Tris–HCl buffer (pH 7.0) and an appropriate amount of enzyme was incubated at 37 °C for 30 min and then the reaction was stopped by adding 1 ml stop solution (5.5 % FeCl3, 2.0 % HClO4, 2 M HCl). The precipitate was removed by centrifugation, and the absorbance of the supernatant at 535 nm was recorded against a blank identical to the one mentioned above but lacking ATP. The changes of absorbance of 0.01 h−1 at 535 nm were defined as one unit (U) of GK activity, and the specific enzyme activity was expressed as U mg−1 protein.
Fresh calli (0.5 g) were homogenized in the ice-cold extraction buffer (100 mM sodium phosphate, 1 mM cysteine and 0.1 mM EDTA, pH 8.0). After centrifugation at 15,000g for 10 min at 4 °C, the supernatant was used as crude enzyme preparation for the measurement of PDH activity. PDH activity was measured as described by Rena and Splittstoesser (1975) with a slight modification. In brief, the crude extraction was incubated in the reaction buffer (100 mM Na2CO3-NaHCO3, 10 mM nicotinamide adenine dinucleotide (NAD), 20 mM l-proline, pH 10.3) at 32 °C for 5 min, and then PDH dependent NAD reduction was monitored at 340 nm for 4 min. One unit (U) of PDH activity was defined as an absorbance change of 0.001 min−1 and the specific enzyme activity was expressed as U mg−1 protein.
H2O2 content measurement
After 6 days of culture on MS medium containing 0.3 mg l−1 6-BA, 1 mg l−1 NAA and various NaCl concentrations (0, 75, 150 and 300 mM), calli were collected for the measurement of H2O2 level according to the method of Sergiev et al. (1997) as described in detail previously by Yang et al. (2010b).
Determination of calcium content
Calli cultured for 0.25, 0.5, 1, 3 and 6 days on MS medium containing 0.3 mg l−1 6-BA, 1 mg l−1 NAA and different NaCl concentrations (0, 75, 150 or 300 mM) were collected for the measurement of Ca content. Element ratio measurement was performed using a scanning electron microscope (Philips Electronics N.V., Eindhalen, the Netherlands) fitted with a Kevex energydispersive X-ray detector (Kenex, Valencia, CA, USA) as described by Vázquez et al. (1999) with some modifications. Calli were placed directly on the aluminum stage and quickly frozen under vacuum. The examination time of each sample was less than 10 min to avoid cell distortion. At least four to five cells per sample were examined. The results were calculated and the atomic number for a particular element in a given cell was expressed as a percentage of the total atomic number for all the elements measured (K, Na, Ca, Mg, P, S and Cl) in the cell.
After treatment with 0, 75 and 150 mM NaCl for 1 day, calli were collected for Ca2+ measurements according to Wu et al. (2002) with some modifications. Calli (15–20 g dry weight) were thoroughly washed with deionized water and dried at 60 °C for 3 days. The dry sample was extracted with 3 N HCl and ion content was determined with an Inductive Coupled Plasma Emission Spectrometer (ICP, LABTAM8410).
Soluble protein content determination
The amount of soluble proteins was estimated according to the method of Bradford (1976) using bovine serum albumin as a standard.
Statistical analysis
Each experiment was repeated at least three times. Values were expressed as mean ± standard error (SE). Statistical comparisons were carried out using SPSS 13.0 software, and the treatment means were compared by using Duncan’s multiple range test (DMRT) at p < 0.05.
Results
Effect of NaCl on proline content
Figure 1a shows the effect of NaCl on the level of proline in calli of Nitraria tangutorum Bobr.. During the early period of salt treatment, proline content increased significantly with the increase of NaCl concentrations and the maximal proline level reached 242 % of the control in calli after treatment with 300 mM NaCl for 3 days. However, proline content decreased with the duration of NaCl treatment. For example, there was about 44 % enhancement in the level of proline after 75 mM NaCl treatment for 3 days, but at the end of 75 mM NaCl treatment (9 days), no significant difference in proline content was observed, as compared with the control. Under 300 mM NaCl stress for 3, 6 and 9 days, the amount of proline was about 242, 172 and 156 % of the control, respectively.
Changes of proline content (a), and ornithine-δ-aminotransferase (OAT, b), glutamyl kinase (GK, c) and proline dehydrogenase (PDH, d) activities induced by NaCl treatment in calli of Nitraria tangutorum Bobr.. Data represent mean ± SE of at least three independent measurements. Within each day, different letters indicate significant differences at p < 0.05
Effects of NaCl on OAT, GK and PDH activities
The treatment of Nitraria tangutorum Bobr. calli with salinity led to a notable elevation of OAT activity (Fig. 1b). During the whole stress period, the maximal OAT activity was observed after treatment with NaCl for 6 days, while the increase rate of this enzyme activity decreased with prolonging stress time. Under 75 mM NaCl stress, OAT activity was 1.92, 2.04 and 1.23 folds of the control values in calli cultured for 3, 6 and 9 days, respectively. Further elevation of OAT activity was observed at 3, 6 and 9 days of 150 mM NaCl treatment, with approximately 2.45-, 2.73- and 1.92-fold increases as compared with the control, respectively.
In contrast to OAT, the treatment of NaCl induced significant decrease in GK activity (Fig. 1c). After exposuring calli to 75 mM NaCl for 3, 6 and 9 days, we found about 27, 36 and 38 % decrease in GK activity as compared with the control, respectively. A further decrease in GK activity was detected when calli were stressed with 150 mM NaCl.
Figure 1d shows the changes of PDH activity during the whole stress period. After 3 days of 75 and 150 mM NaCl treatment, PDH activity decreased about 24 and 31 % in comparison with the control, respectively, while 22 and 19 % reduction of this enzyme activity was induced in calli with prolonging NaCl treatment (6 days). After treatment with 75 and 150 mM NaCl for 9 days, PDH activity increased about 16 and 7 % of the control values, respectively (Fig. 1d), and the slight increase under only 75 mM NaCl treatment showed a significant difference in comparison with the unstressed level (p < 0.05).
NaCl-induced H2O2 production might be involved in the regulation of proline accumulation
The effect of 75 mM NaCl treatment on H2O2 production is shown in Fig. 2a. H2O2 concentration significantly increased in Nitraria tangutorum Bobr. calli with the duration of NaCl treatment, and a maximal increase was detected in NaCl-6 day-treated calli, with about 51 % elevation in comparison with control calli. Application of H2O2 scavengers DMTU and pyruvate could significantly reduce the increase of H2O2 content in salt-treated calli (Fig. 2b).
a Levels of H2O2 in Nitraria tangutorum Bobr. calli under salinity stress. b Effects of dimethylthiourea (DMTU) or pyruvate on NaCl-induced increase of H2O2 content in Nitraria tangutorum Bobr. calli exposed to 75 mM NaCl for 6 days. Control content of H2O2 (100 %) corresponded to 94.86 ± 9.62 ng g−1 Fw and 56.61 ± 1.25 ng g−1 Fw in untreated calli growing for 3 and 6 days, respectively. Values represent the means of at least three replicates for each treatment, bars with different letters are significantly different at the 0.05 level
To confirm the relationship between H2O2 production and proline accumulation, the changes of proline content were measured in calli treated with 75 mM and 150 mM NaCl in the presence of H2O2 scavenger DMTU. Compared to the control, the treatment of 75 mM NaCl for 3 and 6 days induced a notable increase in proline content, but no significant difference in proline content after treatment of the calli with 75 mM NaCl was observed in the presence of 5 mM DMTU. The similar results were found in calli exposed to 150 mM NaCl treatment in the absence and in the presence of 5 mM DMTU (Fig. 3a). The application of pyruvate also reversed NaCl-induced increase of proline level when calli were exposed to 75 mM and 150 mM NaCl for 6 days (Fig. 3b).
Effects of 5 mM dimethylthiourea (DMTU, a) or 5 mM pyruvate (b) on salinity-induced elevation of proline level in calli of Nitraria tangutorum Bobr. after treatment for 3 or 6 days. 0, Control; 75, 75 mM NaCl; 150, 150 mM NaCl; 5, 5 mM pyruvate. Values represent the means of at least three replicates for each treatment, bars with different letters are significantly different at the 0.05 level
Since the stimulation of OAT and the inhibition of PDH in response to salinity might be responsible for proline accumulation, we further investigated the effects of DMTU and pyruvate on the activities of these enzymes in salinity-treated calli. As shown in Fig. 4a, the increase of OAT activity was partly blocked by the addition of 5 mM DMTU or pyruvate in calli treated with 75 mM NaCl for 6 days, as compared with salinity treatment alone. However, the presence of DMTU and pyruvate did not show significant effects on salinity-induced decrease of PDH activity (Fig. 4b).
Effects of dimethylthiourea (DMTU) or pyruvate on salinity induced changes of OAT (a) and PDH (b) activities in calli of Nitraria tangutorum Bobr.. Calli were treated with 75 mM NaCl for 6 days in the absence or presence 5 mM DMTU or 5 mM pyruvate, and the enzyme activities were assayed. Values represent the means of at least three replicates for each treatment, bars with different letters are significantly different at the 0.05 level
Effect of NaCl on calcium content
As revealed in Fig. 5a, the amount of Ca was about 14.94, 21.65 and 21.63 % in control calli cultured for 1, 3 and 6 days, respectively, suggesting that Ca content increased with prolonging the culture. In comparison with the control, Ca percentage in calli increased about 49, 35 and 37 % after 75 mM NaCl treatment for 6, 12 and 24 h, respectively. However, after 3 and 6 days of NaCl treatment, about 24 and 30 % decrease of Ca percentage was induced as compared with the control, respectively. Likewise, measurement of Ca2+ content using an Inductive Coupled Plasma Emission Spectrometer showed that after 1 day of culture NaCl-treated calli accumulated more Ca2+ content than the untreated calli (Fig. 5b).
a Determination of calcium (Ca) percentage in Nitraria tangutorum Bobr. calli with X-ray microanalysis. b Measurements of Ca2+ contents in Nitraria tangutorum Bobr. calli treated with NaCl for 1 day using an Inductive Coupled Plasma Emission Spectrometer. Values represent the means of at least three replicates for each treatment, bars with different letters are significantly different at the 0.05 level
NaCl-induced calcium signal might be associated with proline accumulation
Further work was required to understand the relationship between Ca and NaCl-induced proline accumulation. As shown in Fig. 6, the addition of 4 mM EGTA abolished the enhancement of the amount of proline induced by NaCl treatment for 3 days, suggesting that Ca might be necessary to regulate proline accumulation in Nitraria tangutorum Bobr. calli when exposed to salinity. Additionally, when calli were treated with NaCl together with Ca channel blocker verapamil, NaCl-induced elevation in proline level was also reversed (Fig. 6), further demonstrating that Ca signal was responsible for proline accumulation in response to salinity.
Effects of EGTA and verapamil on salinity-induced enhancement of proline content in calli of Nitraria tangutorum Bobr. after treatment for 3 days. 75, 75 mM NaCl; 150, 150 mM NaCl; EG, 5 mM EGTA; V, 10 μM verapamil. Values represent the means of at least three replicates for each treatment, bars with different letters are significantly different at the 0.05 level
Discussion
Proline is an organic molecule and accumulates in plants when exposed to stress conditions including salinity (Zhao et al. 2009; Wang et al. 2011). In accordance with the research results, the present data exhibited notable increases in proline levels in Nitraria tangutorum Bobr. calli growing on medium containing different NaCl concentrations (Fig. 1a). Because proline can provide protection for plants against osmotic stress, oxidative damage and membrane integrity (Ozden et al. 2009; Pei et al. 2010), proline accumulation is believed to represent an important cellular mechanism for salinity tolerance (Kavi Kishor et al. 2005). More recently, a correlation between the proline accumulation and abiotic stress tolerance has been suggested in different halophytes and cell cultures (Lokhande et al. 2010; Sekmen et al. 2012). However, in Hordeum vulgare L., proline content is not correlated with salt tolerance (Patterson et al. 2009). Furthermore, Lv et al. (2011) reported that proline-overproducing plants showed the growth inhibition and the lower survival rate in response to stress environment. Therefore, further studies will be needed to better understand the relationship between proline accumulation and salinity tolerance in Nitraria tangutorum Bobr. calli.
The enhancement of proline content related to stress conditions has been suggested to achieve through different metabolic mechanisms, such as proline biosynthesis via both glutamate and ornithine pathways. Some investigations support the conclusion that the glutamate pathway, rather than the ornithine pathway, plays a vital role in proline accumulation (Roosens et al. 1999; Zhen and Ma 2009) because increased GK and decreased OAT activities were observed when plants were exposed to stress conditions. The study of Funck et al. (2008) showed that proline content is not affected in OAT Arabidopsis mutants, indicating that OAT is not related to proline accumulation. However, Krell et al. (2007) reported that the ornithine pathway, via an increase of OAT activity, contributes to proline synthesis in plants exposed to salinity treatment. In agreement with this finding, the present data showed that NaCl induced significant elevation of OAT activity but notable decrease of GK activity in Nitraria tangutorum Bobr. calli, suggesting that the ornithine pathway involving in the stimulation of OAT may be responsible for proline accumulation in response to NaCl treatment. Apart from proline biosynthesis, proline content is also determined by proline catabolism occurring in mitochondrial via the action of the enzyme PDH (Szabados and Savouré 2010). The studies of Kumar et al. (2003) and Wang et al. (2011) indicated a positive correlation between increased proline content and reduced PDH activity in response to salt stress in plant seedlings. In Nitraria tangutorum Bobr. calli, the treatment with NaCl for 3 or 6 days resulted in a significant decrease in PDH activity, but a significant increase in this enzyme activity was observed when calli were exposed to 75 mM NaCl for 9 days (Fig. 1d). Moreover, the changes of increase rate in OAT activity and decrease rate in PDH activity were correlated with the increase rate of proline content in calli at the same period of NaCl stress. Thus, the present data confirmed that in Nitraria tangutorum Bobr. calli the enhancement of proline synthese via the stimulation of OAT activity and the reduction of proline catabolism via the inhibition of PDH activity contribute to proline accumulation under salinity stress.
H2O2 accumulation is caused when plants are exposed to abiotic stresses including salinity (Hasegawa et al. 2000). Nitraria tangutorum Bobr. calli treated with 75 mM NaCl showed an increased H2O2 production with the duration of salt stress (Fig. 2a). Excessive H2O2 in cells can lead to oxidative stress, which damages biological membranes and some larger molecules (Forman 2007). On the other hand, H2O2 can be viewed as a signal molecule involved in different physiological processes (Forman 2007; Yang et al. 2007). A recent study has suggested that H2O2 may participate in signal transduction events involved in the regulation of proline metabolism (Yang et al. 2009). Differently, proline accumulation and decreased H2O2 generation in response to different stresses were observed by Simova-Stoilova et al. (2008) and Azzedine et al. (2011). By measuring the amount of proline in the absence or presence of 5 mM DMTU (a hydroxyl radical and H2O2 scavenger that is able to inactivate ROS) and pyruvate (an efficient and specifical H2O2 scavenger via oxidative dephosphorylation), our investigation indicated that proline accumulation was a consequence of increasing H2O2 generation from salinity-stressed calli. It was further supported by the decreased H2O2 level in calli treated with NaCl together DMTU or pyruvate in comparison with calli treated with salinity alone (Fig. 2b). Moreover, no significant effects on the activities of proline metabolic enzymes were observed in calli under DMTU or pyruvate treatments alone (data not shown). However, these two regents prevented the enhancement of OAT activity but did not affect the PDH activity induced by NaCl treatment for 6 days (Fig. 4). According to the preceding findings, we conclude that proline accumulation in response to the increase of H2O2 generation might be caused by the stimulation of OAT in salinity-treated calli.
Serving as an important messenger, Ca plays a fundamental role in regulating polar growth of cells and tissues as well as participates in plant adaptation to various stress factors including salinity stress (Lee and Liu 1999; Song et al. 2008). It has been indicated that Ca2+ supplement enhances NaCl stress-induced proline accumulation in Oryza sativa L. spp. indica (Cha-um et al. 2012) and in Sorghum bicolor roots (Colmer et al. 1996). However, the addition of 10 mM Ca2+ together with NaCl treatment reduces the accumulation of proline in leaf tissues of red-osier dogwood (Renault and Affifi 2009). These studies provide the evidence that exogenous Ca supplement can regulate proline levels in high plants exposed to salinity stress, whereas the conclusions are different, and even contradictory. Moreover, a previous study has indicated that endogenous Ca2+ is negatively associated with NaCl-induced proline accumulation in U. fasciata (Lee and Liu 1999). In the present investigation, Ca2+ chelator EGTA could reverse the enhanced proline content after treatment with 75 mM NaCl for 3 days (Fig. 6), suggesting that Ca might be related to proline accumulation in Nitraria tangutorum Bobr. calli when exposed to salinity. High salinity can regulate the concentration of Ca2+ in plant cells and tissues (Halperin et al. 1997). Increased Ca content in plants during salt stress was reported by different authors (Gao et al. 2004; Yang et al. 2007). In contrast to these conclusions, Lee and Liu (1999) observed that increasing NaCl concentration could result in a fast decrease in the amount of Ca2+ in U. Fasciata. In Nitraria tangutorum Bobr. calli, we found a significantly enhanced Ca content during the early stage of 75 mM NaCl treatment (from 6 h to 24 h), but with the duration of salinity treatment (3 and 6 days) increasing, there was a decrease of Ca content in calli (Fig. 5a). It has been indicated that increased cytosolic Ca2+ may be induced by Ca2+ influx to the cytosol from the apoplast across the plasma membrane (White and Broadley 2003). In this study, 10 μM verapamil, a Ca channel blocker, also reduced the increase of proline level in calli treated by salinity (Fig. 6). This result further demonstrated that Ca signal via the influx of Ca2+ from the apoplast across the plasma membrane was responsible for proline accumulation in response to salinity. Based on the above results, we presumed that the enhancement in Ca content might be attributed to the increased generation of H2O2 from salinity-stressed calli, and that proline accumulation was partly due to the increased Ca content in response to NaCl treatment.
In conclusion, our results indicate that NaCl treatment induces increased level of proline in Nitraria tangutorum Bobr. calli, and this is due to the enhancement of OAT activity and the decrease of PDH activity in response to salinity. In addition, the increased Ca signal during the early stage of NaCl treatment and the stimulation of OAT resulting from the elevation of H2O2 generation are essential for proline accumulation in salinity-stressed calli.
Abbreviations
- ABA:
-
Abscisic acid
- Ca:
-
Calcium
- DMTU:
-
Dimethylthiourea
- GK:
-
Glutamyl kinase
- EDTA:
-
Ethylenediamine tetraacetic acid
- EGTA:
-
Ethylene glycol bis-(beta-aminoethyl ether)-N,N,N′,N′-tetra-acetic acid
- H2O2 :
-
Hydrogen peroxide
- MS:
-
Murashige and Skoog
- OAT:
-
Ornithine δ-aminotransferase
- PDH:
-
Proline dehydrogenase
References
Ashour NI, Mekki BB (2006) Halophytic forage plants in response to irrigation with diluted seawater. World J Agric Sci 2:169–173
Ashraf M (1989) The effect of NaCl on water relations, chlorophyll and protein and proline contents of two cultivars of blackgram (Vigna mungo L.). Plant Soil 119:205–210
Azzedine F, Gherroucha H, Baka M (2011) Improvement of salt tolerance in durum wheat by ascorbic acid application. J Stress Physiol Biochem 7:27–37
Banu MNA, Hoque MA, Watanabe-Sugimoto M, Matsuoka K, Nakamura Y, Shimoishi Y, Murata Y (2009) Proline and glycinebetaine induce antioxidant defense gene expression and suppress cell death in cultured tobacco cells under salt stress. J Plant Physiol 166:146–156
Bates LS, Waldren RP, Teare ID (1973) Rapid determination of free proline for water-stress studies. Plant Soil 39:205–207
Bradford MM (1976) A rapid and sensitive method for the quantitation of microgram quantities of protein utilizing the principle of protein-dye binding. Anal Biochem 72:248–254
Cha-um S, Singh HP, Samphumphuang T, Kirdmanee C (2012) Calcium-alleviated salt tolerance in indica rice (Oryza sativa L. spp. indica): physiological and morphological changes. Aust J Crop Sci 6:176–182
Chen M, Wei H, Cao J, Liu R, Wang Y, Zheng C (2007) Expression of bacillus subtilis proBA genes and reduction of feedback inhibition of proline synthesis increases proline production and confers osmotolerance in transgenic Arabidopsis. J Biochem Mol Biol 40:396–403
Colmer TD, Fan TWM, Higashi RM, Lauchli A (1996) Interactive effects of Ca2+ and NaCl salinity on the ionic relations and proline accumulation in the primary root tip of Sorghum bicolor. Physiol Plant 97:421–424
Du NX, Li X, Li Y, Chen SY, Zhang JS, Ha D, Deng WG, Sun CK, Zhang YZ, Pijut PM (2012) Genetic transformation of Populus tomentosa to improve salt tolerance. Plant Cell Tiss Organ Cult 108:181–189
Forman HJ (2007) Use and abuse of exogenous H2O2 in studies of signal transduction. Free Radical Biol Med 42:926–932
Funck D, Stadelhofer B, Koch W (2008) Ornithine-δ-aminotransferase is essential for arginine catabolism but not for proline biosynthesis. BMC Plant Biol 8:40
Gao D, Knight MR, Trewavas AJ, Sattelmacher B, Plieth C (2004) Self-reporting Arabidopsis expressing pH and [Ca2+] indicators unveil ion dynamics in the cytoplasm and in the apoplast under abiotic stress. Plant Physiol 134:898–908
Gleeson D, Lelu-Walter MA, Parkinson M (2005) Overproduction of proline in transgenic hybrid larch (Larixx leptoeuropaea (Dengler)) cultures renders them tolerant to cold, salt and frost. Mol Breeding 15:21–29
Halperin SJ, Kochian LV, Lynch JP (1997) Salinity stress inhibits calcium loading into the xylem of excised barley (Hordeum vulgare) roots. New Phytol 135:419–427
Hasegawa PM, Bressan RA, Zhu JK, Bohnert HJ (2000) Plant cellular and molecular responses to high salinity. Annu Rev Plant Biol 51:463–499
Kavi Kishor PB, Sangam S, Amrutha RN, Laxmi PS, Naidu KR, Rao K, Rao S, Reddy KJ, Theriappan P, Sreenivasulu N (2005) Regulation of proline biosynthesis, degradation, uptake and transport in higher plants: its implications in plant growth and abiotic stress tolerance. Curr Sci 88:424–438
Kim HR, Rho HW, Park JW, Park BH, Kim JS, Lee MW (1994) Assay of ornithine aminotransferase with ninhydrin. Anal Biochem 223:205–207
Krell A, Funck D, Plettner I, John U, Dieckmann G (2007) Regulation of proline metabolism under salt stress in the psychrophilic diatom Fragilariopsis cylindrus (Bacillariophyceae). J Phycol 43:753–762
Kumar SG, Reddy AM, Sudhakar C (2003) NaCl effects on proline metabolism in two high yielding genotypes of mulberry (Morus alba L.) with contrasting salt tolerance. Plant Sci 165:1245–1251
Lee TM, Liu CH (1999) Correlation of decreased calcium contents with proline accumulation in the marine green macroalga Ulva fasciata exposed to elevated NaCl contents in seawater. J Exp Bot 50:1855–1862
Lokhande VH, Nikam TD, Penna S (2010) Biochemical, physiological and growth changes in response to salinity in callus cultures of Sesuvium portulacastrum L. Plant Cell Tiss Organ Cult 102:17–25
Lutts S, Majerus V, Kinet JM (1999) NaCl effects on proline metabolism in rice (Oryza sativa) seedlings. Physiol Plant 105:450–458
Lv WT, Lin B, Zhang M, Hua XJ (2011) Proline accumulation is inhibitory to Arabidopsis seedlings during heat stress. Plant Physiol 156:1921–1933
Madan S, Nainawatee HS, Jain RK, Chowdhury JB (1995) Proline and proline metabolising enzymes in in vitro selected NaCl-tolerant Brassica juncea L. under salt stress. Ann Bot 76:51–57
Megdiche W, Amor NB, Debez A, Hessini K, Ksouri R, Zuily-Fodil Y, Abdelly C (2007) Salt tolerance of the annual halophyte Cakile maritima as affected by the provenance and the developmental stage. Acta Physiol Plant 29:375–384
Misra N, Gupta AK (2005) Effect of salt stress on proline metabolism in two high yielding genotypes of green gram. Plant Sci 169:331–339
Ozden M, Demirel U, Kahraman A (2009) Effects of proline on antioxidant system in leaves of grapevine (Vitis vinifera L.) exposed to oxidative stress by H2O2. Scientia Hort 119:163–168
Parre E, Ghars MA, Leprince AS, Thiery L, Lefebvre D, Bordenave M, Richard L, Mazars C, Abdelly C, Savoure A (2007) Calcium signaling via phospholipase C is essential for proline accumulation upon ionic but not nonionic hyperosmotic stresses in Arabidopsis. Plant Physiol 144:503–512
Patterson JH, Newbigin E, Tester M, Bacic A, Roessner U (2009) Metabolic responses to salt stress are described for two barley (Hordeum vulgare L.) cultivars, Sahara and Clipper, which differed in salinity. J Exp Bot 60:4089–4103
Pei ZF, Ming DF, Liu D, Wan GL, Geng XX, Gong HJ, Zhou WJ (2010) Silicon improves the tolerance to water-deficit stress induced by polyethylene glycol in wheat (Triticum aestivum L.) seedlings. J Plant Growth Regul 29:106–115
Perez-Alfocea F, Balibrea ME, Cruz AS, Estan MT (1996) Agronomical and physiological characterization of salinity tolerance in a commercial tomato hybrid. Plant Soil 180:251–257
Rena AB, Splittstoesser WE (1975) Proline dehydrogenase and pyrroline-5-carboxylate reductase from pumpkin cotyledons. Phytochem 14:657–661
Renault S, Affifi M (2009) Improving NaCl resistance of red-osier dogwood: role of CaCl2 and CaSO4. Plant Soil 315:123–133
Roosens NH, Willem R, Li Y, Verbruggen II, Biesemans M, Jacobs M (1999) Proline metabolism in the wild-type and in a salt tolerant mutant of Nicotiana plumbaginifolia studied by 13C-nuclear magnetic resonance imaging. Plant Physiol 121:1281–1290
Savoure A, Hua XJ, Bertauche N, Montagu MV, Verbruggen N (1997) Abscisic acid-independent and abscisic acid-dependent regulation of proline biosynthesis following cold and osmotic stresses in Arabidopsis thaliana. Mol Gen Genet 254:104–109
Sekmen AH, Turkan I, Tanyolac ZO, Ozfidan C, Dinc A (2012) Different antioxidant defense responses to salt stress during germination and vegetative stages of endemic halophyte Gypsophila oblanceolata Bark. Environ Exp Bot 77:63–76
Sergiev I, Alexieva V, Karanov E (1997) Effect of spermine, atrazine and combination between them on some endogenous protective systems and stress markers in plants. Compt Rend Acad Bulg Sci 51:121–124
Simova-Stoilova L, Demirevska K, Petrova T, Tsenov N, Feller U (2008) Antioxidative protection in wheat varieties under severe recoverable drought at seedling stage. Plant Soil Environ 54:529–536
Smith CJ, Deutch AH, Rushlow KE (1984) Purification and characteristics of a γ-glutamyl kinase involved in Escherichia coli proline biosynthesis. J Bacteriol 157:545–551
Song WY, Zhang ZB, Shao HB, Guo XL, Cao HX, Zhao HB, Fu ZY, Hu XJ (2008) Relationship between calcium decoding elements and plant abiotic-stress resistance. Int J Biol Sci 4:116–125
Szabados L, Savouré A (2010) Proline: a multifunctional amino acid. Trends Plant Sci 15:89–97
Thiery L, Leprince AS, Lefebvre D, Ghars MA, Debarbieux E, Savouré A (2004) Phospholipase D is a negative regulator of proline biosynthesis in Arabidopsis thaliana. J Biol Chem 279:14812–14818
Vázquez MD, Poschenrieder C, Corrales I, Barceló J (1999) Change in apoplastic aluminum during the initial growth response to aluminum by roots of a tolerant maize variety. Plant Physiol 119:435–444
Wang K, Liu Y, Dong K, Dong J, Kang J, Yang Q, Zhou H, Sun Y (2011) The effect of NaCl on proline metabolism in Saussurea amara seedlings. Afr J Biotechnol 10:2886–2893
White PJ, Broadley MR (2003) Calcium in plants. Ann Bot 92:487–511
Widholm JM (1988) In vitro selection with plant cell and tissue cultures. Iowa State J Res 62:587–595
Wu Z, Liang F, Hong B, Young JC, Sussman MR, Harper JF, Sze H (2002) An endoplasmic reticulum-bound Ca2+/Mn2+ pump, ECA1, supports plant growth and confers tolerance to Mn2+ stress. Plant Physiol 130:128–137
Yang YL, Xu SJ, An LZ, Chen NL (2007) NADPH oxidase-dependent hydrogen peroxide production, induced by salinity stress, may be involved in the regulation of total calcium in roots of wheat. J Plant Physiol 164:1429–1435
Yang SL, Lan SS, Gong M (2009) Hydrogen peroxide-induced proline and metabolic pathway of its accumulation in maize seedlings. J Plant Physiol 166:1694–1699
Yang YL, Wei XL, Shi RX, Fan Q, An LZ (2010a) Salinity-induced physiological modification in the callus from halophyte Nitraria tangutorum Bobr. J Plant Growth Regul 29:477–486
Yang YL, Shi RX, Wei XL, Fan Q, An LZ (2010b) Effect of salinity on antioxidant enzymes in calli of the halophyte Nitraria tangutorum Bobr. Plant Cell Tiss Organ Cult 102:387–395
Zhao X, Tan HJ, Liu YB, Li XR, Chen GX (2009) Effect of salt stress on growth and osmotic regulation in Thellungiella and Arabidopsis callus. Plant Cell Tiss Organ Cult 98:97–103
Zhen WB, Ma QH (2009) Proline metabolism in response to salt stress in common reed [Phragmites australis (Cav.) Trin. ex Steud]. Bot Marina 52:307–315
Acknowledgments
This work was financially supported by the National Natural Science Foundation of China (No. 31160088 and 30960064) and Program for New Century Excellent Talents in University of China.
Author information
Authors and Affiliations
Corresponding author
Rights and permissions
About this article
Cite this article
Yang, Y., Yang, F., Li, X. et al. Signal regulation of proline metabolism in callus of the halophyte Nitraria tangutorum Bobr. grown under salinity stress. Plant Cell Tiss Organ Cult 112, 33–42 (2013). https://doi.org/10.1007/s11240-012-0209-7
Received:
Accepted:
Published:
Issue Date:
DOI: https://doi.org/10.1007/s11240-012-0209-7